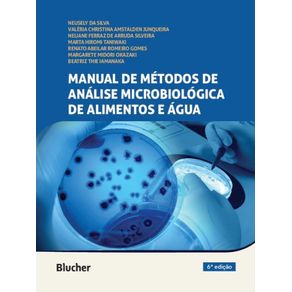
966999.jpg 966999.jpg

De: R$ 0,00Por: R$ 297,00ou X de
Calcule o frete:
Para envios internacionais, simule o frete no carrinho de compras.
Calcule o valor do frete e prazo de entrega para a sua região
Sinopse
Cada capítulo traz uma revisão profunda e atualizada sobre o(s) microrganismo(s) tratado(s), incluindo posição taxonômica, mudanças na nomenclatura, características morfológicas e bioquímicas e epidemiologia. Oferece também comparações esquemáticas entre os métodos disponíveis, destacando suas diferenças e similaridades. A apresentação didática do passo a passo dos métodos em figuras esquemáticas permite uma rápida apreensão dos procedimentos, facilitando sua execução no dia a dia dos laboratórios.
Ficha Técnica
Especificações
| ISBN | 9786555062977 |
|---|---|
| Pré venda | Não |
| Peso | 1557g |
| Autor para link | SILVA NEUSELY DA,JUNQUEIRA VALERIA CHRISTINA AMSTALDEN,SILVEIRA NELIANE FERRAZ DE ARRUDA,TANIWAKI MARTA HIROMI,GOMES RENATO ABEILAR ROMEIRO |
| Livro disponível - pronta entrega | Sim |
| Dimensões | 28 x 21 x 3 |
| Idioma | Português |
| Tipo item | Livro Nacional |
| Número de páginas | 602 |
| Número da edição | 6ª EDIÇÃO - 2021 |
| Código Interno | 966999 |
| Código de barras | 9786555062977 |
| Acabamento | BROCHURA |
| Autor | SILVA, NEUSELY DA | JUNQUEIRA, VALERIA CHRISTINA AMSTALDEN | SILVEIRA, NELIANE FERRAZ DE ARRUDA | TANIWAKI, MARTA HIROMI | GOMES, RENATO ABEILAR ROMEIRO |
| Editora | BLUCHER |
| Sob encomenda | Não |